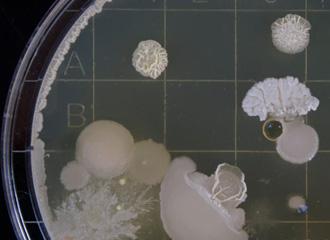

- ES
- EN
Actividades
Comienza el contenido principal

Enfermedades raras de la piel: de la clínica al gen y viceversa
Ciencias de la Vida y de la Materia Simposio Internacional 20 y 21 de octubre de 2016 Madrid
Información general
Sede: Fundación Ramón Areces Vitruvio, 5. 28006 Madrid
Interpretación simultánea
- Asistencia gratuita
- Aforo limitado
Organizado por:
Fundación Ramón Areces
Coordinador/es:
Fernando Larcher Laguzzi CIEMAT-Universidad Carlos III de Madrid-IIS Fundación Jiménez Díaz
Coordinadora adjunta:
Yolanda Gilaberte Hospital San Jorge. Huesca
Multimedia
Síndrome de Netherton: de los modelos animales al paciente
Multimedia
Ensayo clínico de Terapia génica para Síndrome de Netherton
Multimedia
Novedades en Ictiosis
Multimedia
Epidermolisis Bullosa en España
Multimedia
Epidermolisis Bullosa y cáncer
Multimedia
Novedades en el tratamiento de la Epidermolisis Bullosa distrófica
Multimedia
Genes de reparación por escisión en enfermedades con susceptibilidad al cáncer
Multimedia
Displasias ectodérmicas. Correlación fenotipo-genotipo
Multimedia
Nuevos mecanismos de acción de los glucocorticoides. Implicaciones para el tratamiento de enfermedad
Multimedia
Diagnóstico por tecnologías de nueva generación para genodermatosis
Multimedia
Anomalías vasculares congénitas
Multimedia
Susceptibilidad genética en el melanoma esporádico
- Descripción
- Programa
Las enfermedades hereditarias raras de piel, también conocidas como genodermatosis, constituyen cerca del 7-8% de enfermedades raras y en su conjunto representan una parte relevante de la patología y clínica dermatológica. Actualmente las bases genéticas de alrededor de 400 genodermatosis, en su mayoría enfermedades monogénicas, han sido dilucidadas lo cual permite una clasificación precisa, su diagnóstico molecular y, en mayor o menor medida, la comprensión de sus mecanismos patogénicos. Tal como ocurre con otros tipos de enfermedades raras, a menudo las consecuencias de las genodermatosis para el paciente son devastadoras y/o estigmatizantes. Las genodermatosis se agrupan en:
- Trastornos de la adhesividad epitelial
- De la queratinización/cornificación
- De la pigmentación
- De la reparación del ADN
- Del tejido conectivo
- Displasias ectodérmicas.
A pesar de los avances en el campo, los principales problemas de salud y desafíos que plantea la gran variedad de genodermatosis son: 1) la dificultad del diagnóstico molecular (identificación de mutaciones) de la enfermedad, fundamental para un correcto asesoramiento genético, 2) la caracterización de interacciones moleculares, biomarcadores y patologías secundarias asociados al defecto genético primario y 3) el desarrollo de tratamientos curativos seguros y eficaces basados en el defecto molecular causal. Si bien es imposible abarcar todas las entidades, este simposio acercará a los participantes las novedades en los distintos grandes grupos de genodermatosis y permitirá la interacción entre los máximos expertos nacionales e internacionales en el tema.
El simposio está dividido en 5 apartados y una conferencia plenaria que cubren tanto el estado del arte en el manejo clínico de este conjunto de enfermedades así como la investigación actual y perspectivas futuras.
Se desarrollarán 5 temas principales:
- Enfermedades de la queratinización, incluyendo novedades en la investigación y ensayos clínicos
- Enfermedades de fragilidad dermoepidérmica, haciendo hincapié en su problemática en España, así como en los nuevos abordajes terapéuticos a nivel clínico y pre-clínico
- Enfermedades de reparación del ADN, con el descubrimiento y caracterización de nuevos genes y nuevas líneas de investigación
- Displasias ectodérmicas y la relación entre genotipos y manifestaciones clínicas
- Un apartado de Vasculopatías-cáncer, con origen genético y sus aspectos clínicos más relevantes
Los temas propuestos contemplan los avances más recientes y los ponentes invitados se encuentran entre las figuras más destacadas a nivel nacional e internacional en este campo.
Jueves, 20
9:30
Bienvenida y introducción
Federico Mayor Zaragoza
Presidente del Consejo Científico. Fundación Ramón Areces.
José María Medina
Vicepresidente del Consejo Científico. Fundación Ramón Areces.
Fernando Larcher Laguzzi
Coordinador del Simposio.
Yolanda Gilaberte
Coordinadora adjunta del Simposio.
Pablo Lapunzina
Director científico del CIBER de Enfermedades Raras.
Enfermedades de la queratinización
9:45
Síndrome de Netherton: de los modelos animales al paciente
Alain Hovnanian
INSERM UMR 1163. Institut Imagine. Université Paris Descartes. Hôpital Necker. París. Francia.
10:30
Ensayo clínico de Terapia génica para Síndrome de Netherton
Wei Li Di
University College London. Institute of Child Health. Londres. Reino Unido.
11:15
Novedades en Ictiosis
Heiko Traupe
Klinik für Dermatologie. Universitätsklinikum Münster. Alemania.
12:00
Descanso
Enfermedades de fragilidad dermo-epidérmica
12:15
Epidermolisis Bullosa en España
María José Escámez
Rocío Maseda
CIEMAT-Universidad Carlos III de Madrid-IIS Fundación Jiménez Díaz. CIBER de Enfermedades Raras y Servicio de Dermatología Pediátrica. Hospital Universitario La Paz. Madrid.
12:45
Epidermolisis Bullosa y cáncer
Andrew South
Department of Dermatology and Cutaneous Biology. Jefferson University, Philadelphia. EE. UU.
13:15
Novedades en el tratamiento de la Epidermolisis Bullosa distrófica
Fernando Larcher Laguzzi
CIEMAT-Universidad Carlos III de Madrid-IIS Fundación Jiménez Díaz. Madrid. CIBER de Enfermedades Raras.
14:00
Descanso
Enfermedades de reparación del ADN
16:00
Novedades en la investigación sobre Xeroderma Pigmentoso
Robert Sarkany
St. John's Institute of Dermatology. Londres. Reino Unido.
16:45
Reparación del daño al ADN inducido por UV, transcripción y splicing alternativo
Alberto Kornblihtt
LFBM-IFIBYNE-UBA-CONICET. Universidad de Buenos Aires. Argentina.
17:30
Genes de reparación por escisión en enfermedades con susceptibilidad al cáncer
Jordi Surrallés
Departament de Genética y Microbiología. Universidad Autónoma de Barcelona. CIBER de Enfermedades Raras.
Viernes, 21
Displasias ectodérmicas
9:30
Displasias ectodérmicas. Correlación fenotipo-genotipo
Smail Hadj Rabia
Hôpital Necker Enfants Malades. París. Francia.
10:15
Nuevos mecanismos de acción de los glucocorticoides. Implicaciones para el tratamiento de enfermedades de piel
Paloma Pérez
Instituto de Biomedicina de Valencia (IBV-CSIC).
11:00
Descanso
Conferencia magistral
11:15
Diagnóstico por tecnologías de nueva generación para genodermatosis
John McGrath
King's College London. St John's Institute of Dermatology. Guy's Hospital. Londres. Reino Unido.
Anomalías vasculares - cáncer
12:15
Anomalías vasculares congénitas
Eulalia Baselga
Unidad de Dermatología Pediátrica. Hospital de la Santa Creu i Sant Pau. Barcelona.
12:45
Avances en melanoma familiar
Joan Anton Puig
Departamento de Bioquímica y Genética Molecular. Unidad de Melanoma. Hospital Clínic de Barcelona. CIBER de Enfermedades Raras.
13:15
Susceptibilidad genética en el melanoma esporádico
Eduardo Nagore
Servicio de Dermatología. Instituto Valenciano de Oncología. Valencia.
-
 Actividades relacionadas
Actividades relacionadas
-
 Proyectos relacionados
Proyectos relacionados
-
 Noticias relacionadas
Noticias relacionadas
-
 Publicaciones relacionadas
Publicaciones relacionadas
-
 Blog entradas relacionadas
Blog entradas relacionadas
-
8
abr
2024
Mesa Redonda Mundo de las prótesis, los nuevos materiales, sus complicaciones y su futuro Madrid , Lunes, 8 de abril 2024. 17.00 horas
-
23
abr
2024
Jornada Situación actual de las Enfermedades Raras en España Madrid, Martes, 23 de abril de 2024, 10:00 horas
-
9
may
2024
Conferencia Genes de mosca y genes humanos: una comparación Madrid, Jueves 09 de mayo de 2024, 19:00 horas
- Fenotipación de modelos animales de enfermedades raras con discapacidad visual 2020 Investigador Principal: Lluís Montoliu José Centro de investigación o Institución: Centro Nacional de Biotecnología (CNB). CSIC. Madrid
- El transportador neuronal de glicina GlyT2 en hiperplexia: una patología glicinérgica del desarrollo 2020 Investigador Principal: Beatriz López Corcuera Centro de investigación o Institución: Centro de Biología Molecular Severo Ochoa. CSIC - UAM
- Marcadores séricos en pacientes con nevus melanocíticos congénitos: correlación clínico-patológica y genética 2020 Investigador Principal: Pedro Redondo Bellón Centro de investigación o Institución: Clínica Universidad de Navarra. Pamplona

Terapias celulares: nuevas oportunidades de la mano de la ingeniería genética y la inmunoterapia
2023 Monografías NatureFin del contenido principal